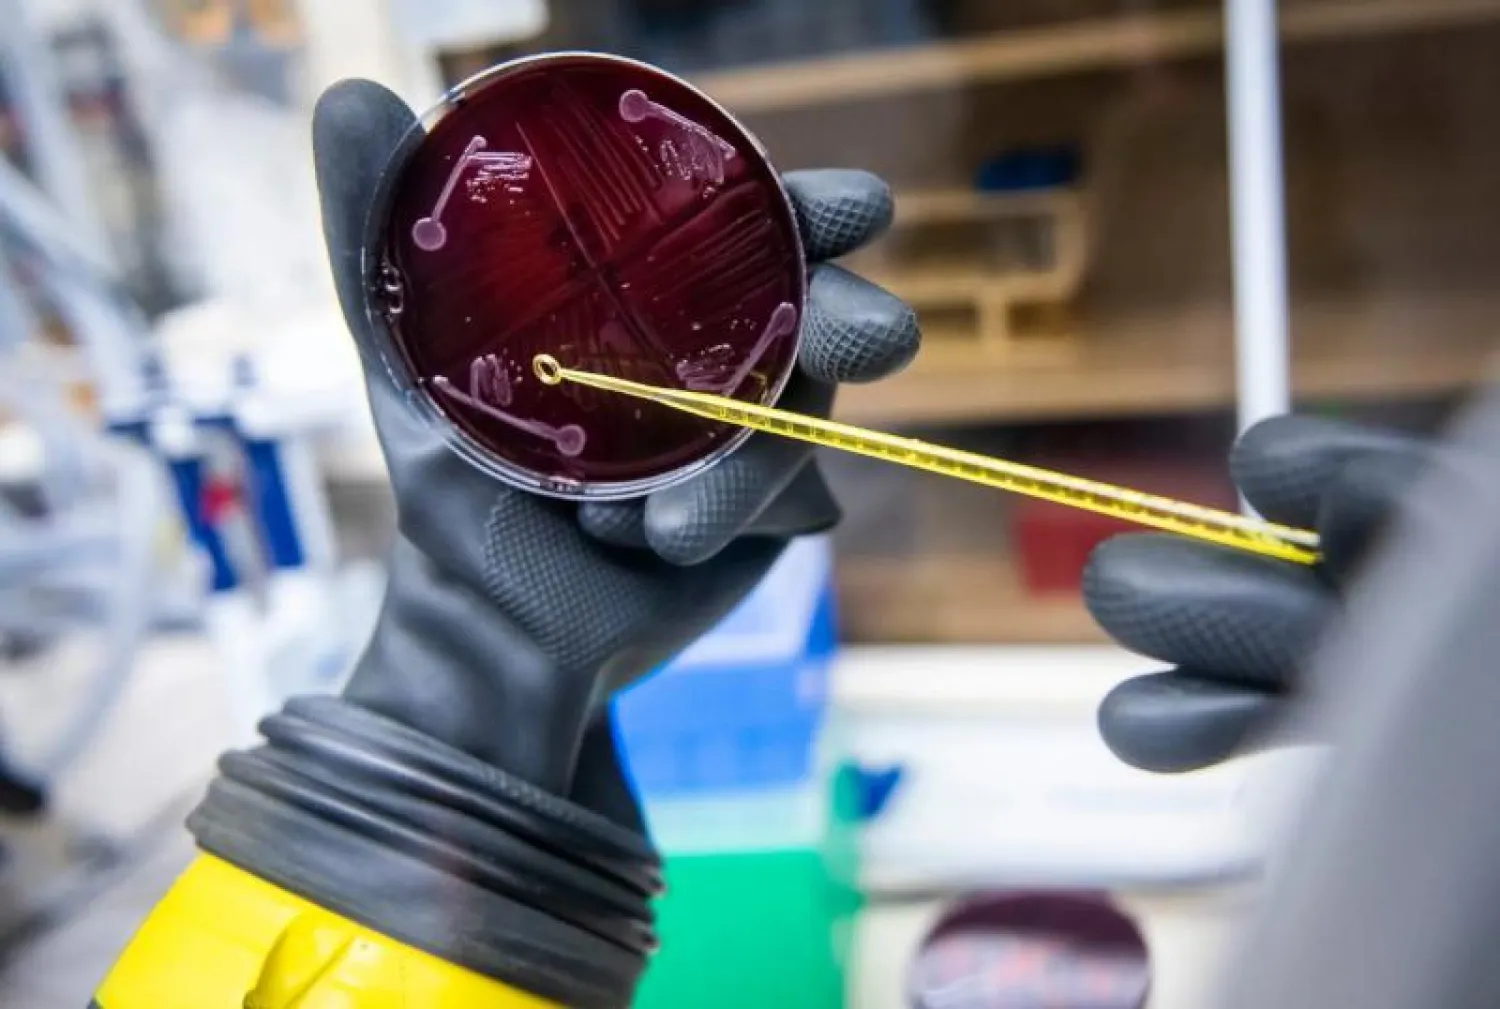
يمكن للميكروبيوم الصناعي الجديد أن يتصدى لمسببات الأمراض العدوانية (نيويورك تايمز)

ابتكر علماء من جامعة ستانفورد الأميركية أول ميكروبيوم بشري صناعي، يجمع بين 119 نوعاً من البكتيريا الموجودة بشكل طبيعي في جسم الإنسان، وأشاروا إلى أن هذا الابتكار يمكن أن تؤدي إلى علاجات لعدوى الأمعاء التي تهدد الحياة.
وتتكون ميكروبيومات الأمعاء من مئات الأنواع البكتيرية التي تعيش في الجهاز الهضمي للإنسان وتلعب دوراً رئيسياً في صحة الإنسان من خلال دعم جهاز المناعة والتحكم في الهضم.
ووفقاً لصحيفة «نيويورك تايمز» الأميركية، فقد طور علماء جامعة ستانفورد مستعمرة من 119 نوعاً من البكتيريا الموجودة في جسم الإنسان، بعد دراستهم لتسلسل الجينومات الميكروبية الكاملة لأكثر من 300 بالغ، ثم تمكنوا بعد ذلك من تحويل هذه البكتيريا في المختبر إلى ميكروبيوم بشري صناعي.
بعد ذلك، وللتأكد من فاعلية نتائجهم، قام العلماء بزرع الميكروبيوم الصناعي في مجموعة من الفئران، حيث استقر بأجسامهم وتضاعف. وحين حقن العلماء القوارض ببكتيريا الإشريكية القولونية التي تعيش عادة في الأمعاء، وجدوا أن الميكروبيوم المزروع حماها من العدوى وأدى إلى تطوير نظام مناعي صحي بأجسامها.
وقال الدكتور مايكل فيشباخ، الذي قاد فريق البحث في بيان: «يمكن للميكروبيوم الصناعي الجديد أن يتصدى لمسببات الأمراض العدوانية ويعالج التهابات الأمعاء المهددة للحياة عن طريق زرعه في أمعاء المرضى».
ولفت فيشباخ إلى أن فريقه يخطط للبحث مستقبلاً في كيفية استخدام الأنواع المختلفة من البكتيريا الموجودة بشكل طبيعي في جسم الإنسان في علاج الأمراض والمشكلات الصحية المختلفة، وليس فقط مشكلات الأمعاء.
ونشرت الدراسة الجديدة أمس (الثلاثاء) في مجلة Cell.
8:27 دقيقه
علماء يطورون أول «ميكروبيوم» بشري صناعي
https://aawsat.com/home/article/3860441/%D8%B9%D9%84%D9%85%D8%A7%D8%A1-%D9%8A%D8%B7%D9%88%D8%B1%D9%88%D9%86-%D8%A3%D9%88%D9%84-%C2%AB%D9%85%D9%8A%D9%83%D8%B1%D9%88%D8%A8%D9%8A%D9%88%D9%85%C2%BB-%D8%A8%D8%B4%D8%B1%D9%8A-%D8%B5%D9%86%D8%A7%D8%B9%D9%8A



علماء يطورون أول «ميكروبيوم» بشري صناعي
يجمع بين 119 نوعاً من البكتيريا الموجودة بالجسم

يمكن للميكروبيوم الصناعي الجديد أن يتصدى لمسببات الأمراض العدوانية (نيويورك تايمز)

علماء يطورون أول «ميكروبيوم» بشري صناعي
يمكن للميكروبيوم الصناعي الجديد أن يتصدى لمسببات الأمراض العدوانية (نيويورك تايمز)
مواضيع
مقالات ذات صلة
لم تشترك بعد
انشئ حساباً خاصاً بك لتحصل على أخبار مخصصة لك ولتتمتع بخاصية حفظ المقالات وتتلقى نشراتنا البريدية المتنوعة

















